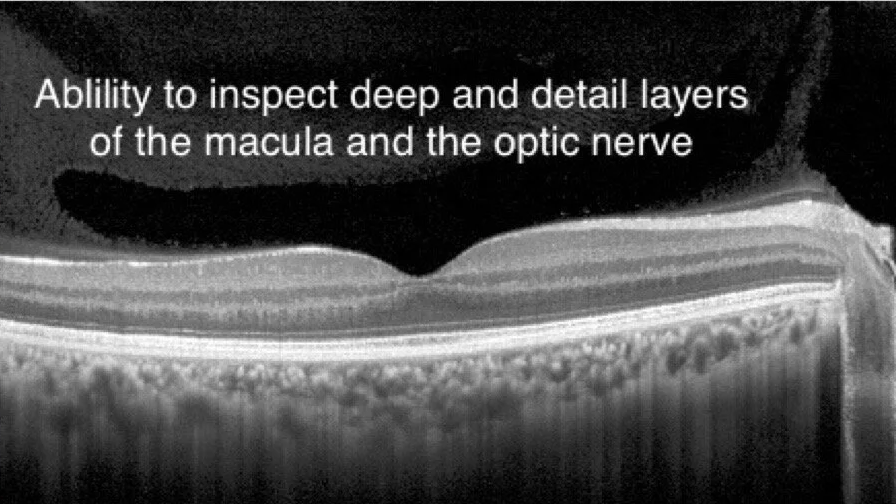

Dr. Hawari and our office have been at the forefront of therapeutic optometry as permitted by state legislation.
This is great for patients because co-management allows patients to stay close to home for pre- and post-op visits such as cataract surgery and for management of eye diseases such as glaucoma, macular degeneration, diabetic retinopathy as well as many others.
Read more about the optometric aspect of our practice here or the optical side here.
To provide the best patient care possible, we offer a host of in-house testing ranging from cutting-edge Optovue Avanti to Virtual Visual Field Testing to Pan-retinal imaging and dry disease testing including Infrared meibography.
“I recently had a patient who did the iVue Screening and due to a small defect we did the full test and caught his early stages of glaucoma 8-10 years earlier than we could even 5 years ago.”
With the complete offering of retina, optic disc, RNFL & GCC, and anterior segment scanning as standard, the Avanti is the perfect advanced, yet easy-to-use OCT for clinical practices. With the ability to screen and detect glaucoma up to five to ten years earlier than standard eye examinations is key in its successful management.
In January of 2002 Mineola Eyecare became the 439th eyecare practice in the world to add the Optomap technology. Since then the pan-retinal imaging has been highly accepted across the world and no considered a standard in many practice. In most cases the imaging can be a replacement for dilation of the eyes. Studies have shown the Optomap can reveal up to 60% more retinal defects, conditions and diseases compared to old methods.
The Optomap retinal exam takes a computer-generated image of the retina, which can be immediately evaluated by Dr. Hawari at Mineola Eyecare. There is no pupil dilation, no eye drops, blurred vision or sensitivity to light. It allows for earlier diagnosis and comparisons over time, which provides better care.
Visit Optomap.com to learn more.
“One of our first patients screened with the Optomap retinal exam came in for his annual eye exam and was not experiencing any symptoms or problems. The Optomap allowed us to see a very early onset of diabetic retinopathy, which may not have been detected using other conventional methods. As a result, we were able to properly diagnose the problem, treat it early and prevent any loss of vision for the patient.”
No more puff of air in Mineola!
VISIT ICARE-USA.COM TO LEARN MORE.
The icare tonometer allows for pressure readings with a barely noticeable rebound technology that eliminates the need for an annoying puff of air. For the moment this is only available in Mineola.
Color Vision diagnostic testing is more than evaluation different degrees of genetic linked color deficiencies. If can be use to determine early decreases in vision cause macular diseases and glaucoma.